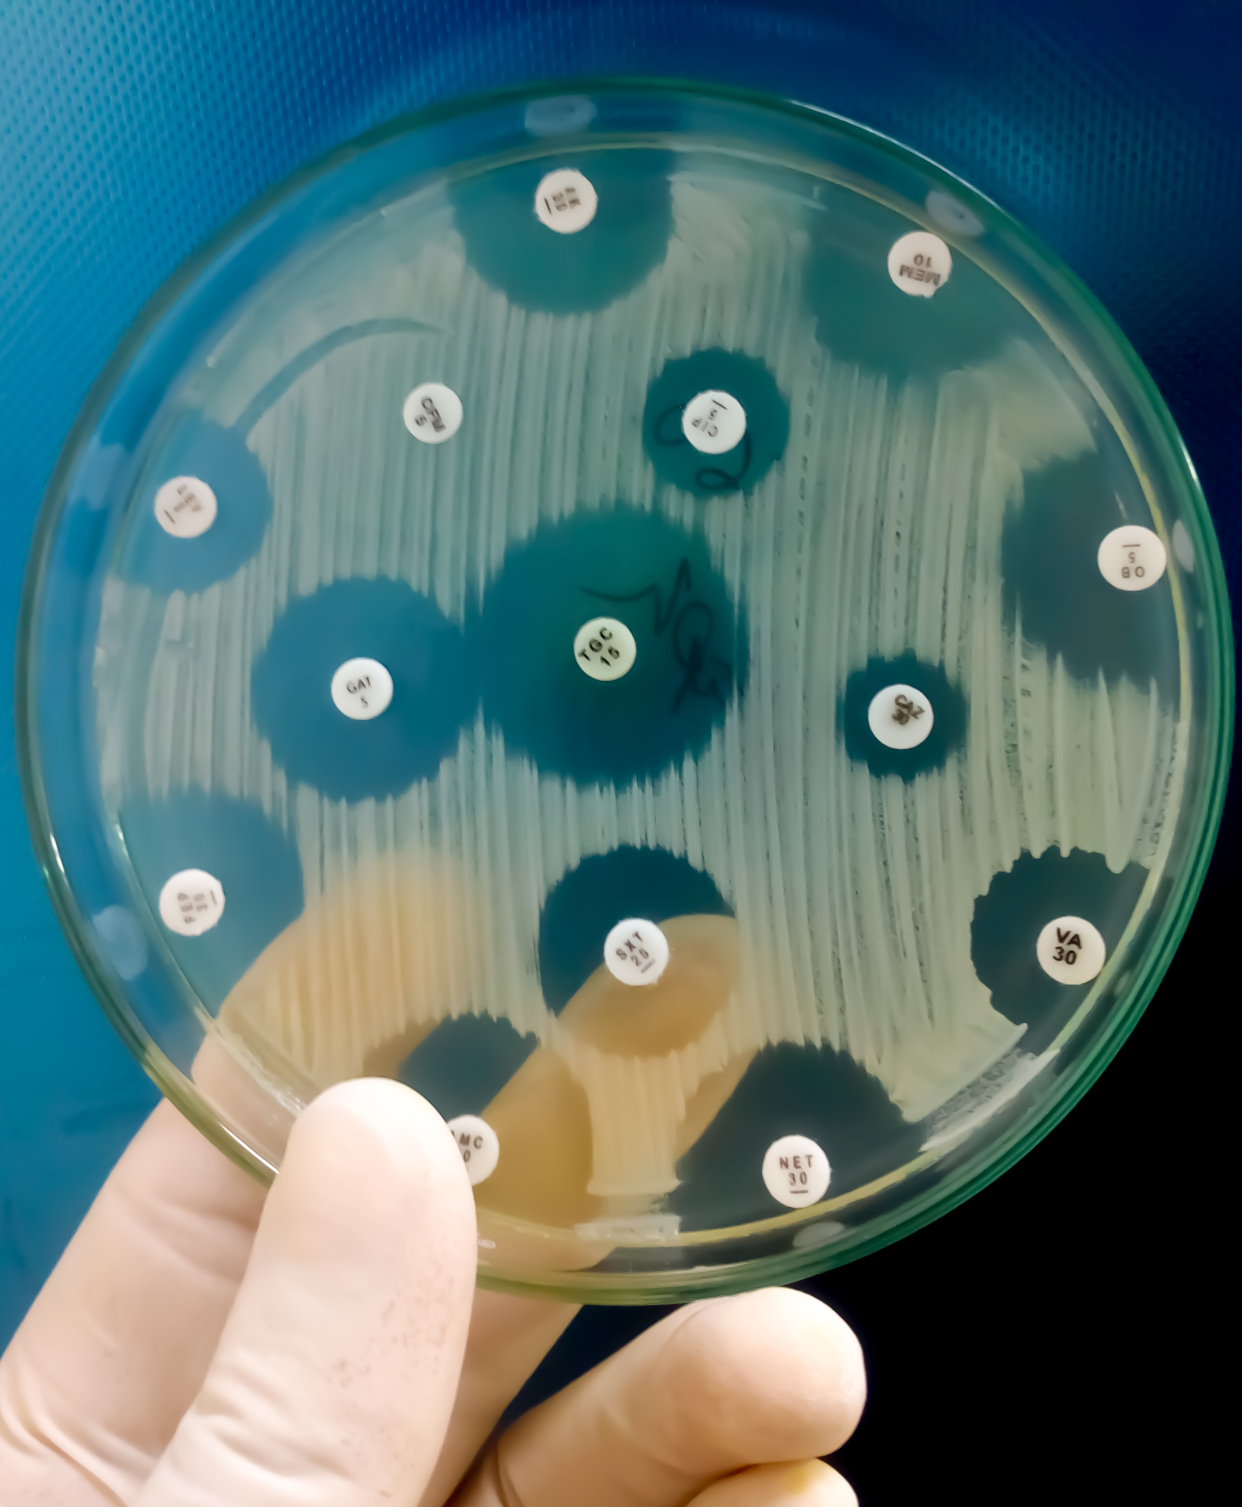

The Biota Trace Environmental Analysis and Surveillance Insights (EASI) ecosystem fuses
molecular, geophysical and physiochemical technologies to map,
capture and analyse the biological and chemical landscape, spanning water
and air.
From event-driven samplers and biochemical data collection to
unmanned surface vessels delivering spatial surveys and geophysical mapping, every stream
of data feeds into EASI — giving current disparate and complex methods simplicity and
clarity. Insights reach you as alerts or comprehensive EASI Reports.
Our approach is flexible, providing complete end-to-end solutions or single work packages
that use single elements of our technologies or services.
Biomonitoring Made EASI
Current Applications
Our Technologies
Our Services
Molecular Analysis & Bioinformatics
Geophysical & Physiochemical

Technology Applications
Our technology and solutions are utilised across a diverse range of
applications delivering
valuable insights into complex biomonitoring challenges.
Use our interactive map and hover over the icons to find out more.
Biota
"the composition of the animals, plants or microbes in a particular place or time"
Trace
"to detect the presence of or locate its origin"
Biota Trace provide next generation biomonitoring solutions to a range of industries and research sectors. At Biota Trace we aim provide the greatest insights into environmental and the biomonitoring landscape. Joined up thinking for a multidisciplinary problem.
Our Approach
At our core we are a science and engineering company. Collaboration and problem solving is our passion. We work with researchers, industry end users and technology suppliers to provide next generation biomonitoring solutions.

Industry
Fast, cost effective and easy to deploy solutions for rapid and actionable biomonitoring insights.

Research
Innovative technology and solutions for laboratory and field-based biomonitoring research.

Collaboration
Our R&D team collaborates with our customers to co-develop innovative biomonitoring solutions.